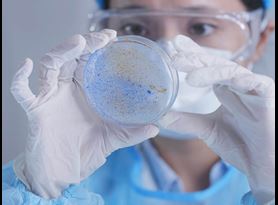
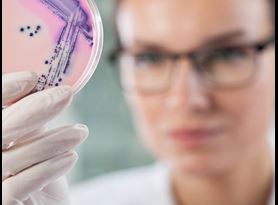

The regulation of antimicrobial pesticide devices is complex, as the EPA or FDA regulate these devices depending on their intended use. Regardless of governing authority, device producers are required to produce efficacy data to support all claims. Successfully navigate the complex regulations for these devices with Element’s consultative regulatory and scientific experts.
Pesticide or antimicrobial devices produce an antimicrobial product or act as the antimicrobial themselves. UV, sterilizing, steam, ozone, infrared, and ionizing devices are all antimicrobial pesticide devices. It is important to note antimicrobial pesticide devices that work by physical means are regulated by the US Environmental Protection Agency (EPA) but do not require registration. We have decades of experience testing to established methods and developing custom protocols. If the method you are interested in is not detailed here, start the conversation to find out how we can meet your needs.
UV device testing
Evaluation of the Antimicrobial Activity of a UV Device for Use on Inanimate Environmental Surfaces - The EPA requires that antimicrobial claims for UV devices be supported by appropriate scientific data demonstrating the efficacy of the device against the claimed organism. This is accomplished in the laboratory by treating the target organism with the test device under conditions which simulate as closely as possible, the actual conditions under which the test device is designed to be used. For products intended for use on hard, inanimate, non-porous surfaces, a carrier method is used in the generation of the supporting data.
A film of organism cells dried on a surface of glass carriers is exposed to the test device for a specified exposure time. Following exposure, the carriers are neutralized and assayed for survivors.
This study is designed to determine the antimicrobial activity of a UV device against specified test organisms. Results are expressed in percent and log10 reduction of the test organism. Minimum percent and log reduction values do not exist to specify a “passing” or “failing” test device.
Sterilizing device testing
Efficacy of a Sterilizing Device - The US Food and Drug Administration (FDA) requires that a Premarket Notification [510(k)] submission for sterilizing devices be supported by appropriate scientific data demonstrating the efficacy of the device against bacterial spore-forming organisms. This is accomplished in the laboratory by treating the target test organism with the sterilizing device under conditions which simulate as closely as possible the actual conditions under which the sterilizing device is designed to be used.
For products intended for use on hard surfaces (dry, inanimate environmental surfaces), a carrier method is used in the generation of the supporting data. The experimental design in this protocol meets these requirements. The test system to be used in this study will follow a modification to AOAC approved method for the determination of the Sporicidal Activity of Disinfectants. Because of its reliability in producing adequate spore titers, Method II has been employed in this protocol to generate Bacillus subtilis spores.
A film of bacterial spores dried on specified carriers is exposed to the test device for a specified exposure time. After exposure, the carriers are transferred to vessels containing neutralizing subculture medium and assayed for survivors. The FDA efficacy performance requirements regarding 510(k) submission for sterilizers used in health care facilities requires killing microorganisms on all inoculated carriers.
Custom antimicrobial pesticide device testing
Custom protocols can be developed to meet your specific device testing needs. Our extensive experience working with a variety of devices includes, but is not limited to, the following:
- UV devices
- Steam cleaning/mopping devices
- Ozone devices
- Infrared light devices
- Ionizers
- Disinfectant generating devices
The Element advantage
Having served as a leader in antimicrobial testing for more than 30 years, Element remains the trusted partner for leading developers, manufacturers, and marketers of antimicrobial pesticide devices. Confidently and successfully navigate and understand regulations for antimicrobial pesticide devices and generate needed data according to microbiology antimicrobial device testing standards with the support of our consultative scientific and regulatory experts. If there is a method you do not see that you're interested in, please reach out. We'd be happy to speak about it.
For more information about Element’s microbiological antimicrobial pesticide device testing, contact us today.
Learn more

Microbiology Testing
Element offers a diverse array of microbiology testing services and can serve clients from early-stage antimicrobial product development and non-GLP screen testing all the way through GLP testing for submission.

Virology Testing
Element offers GLP and cGMP virology testing options to serve our clients in the antimicrobial and pharmaceutical industries.
About Element Eagan
Element Eagan is the premier contract antimicrobial testing laboratory and expert partner to the developers, manufacturers and users of antimicrobial pesticide and biocide products. We have more than 30 years of experience generating GLP-compliant data.
Client Portal
Secure 24/7 access to your test result information, which you can download directly to your information management system.